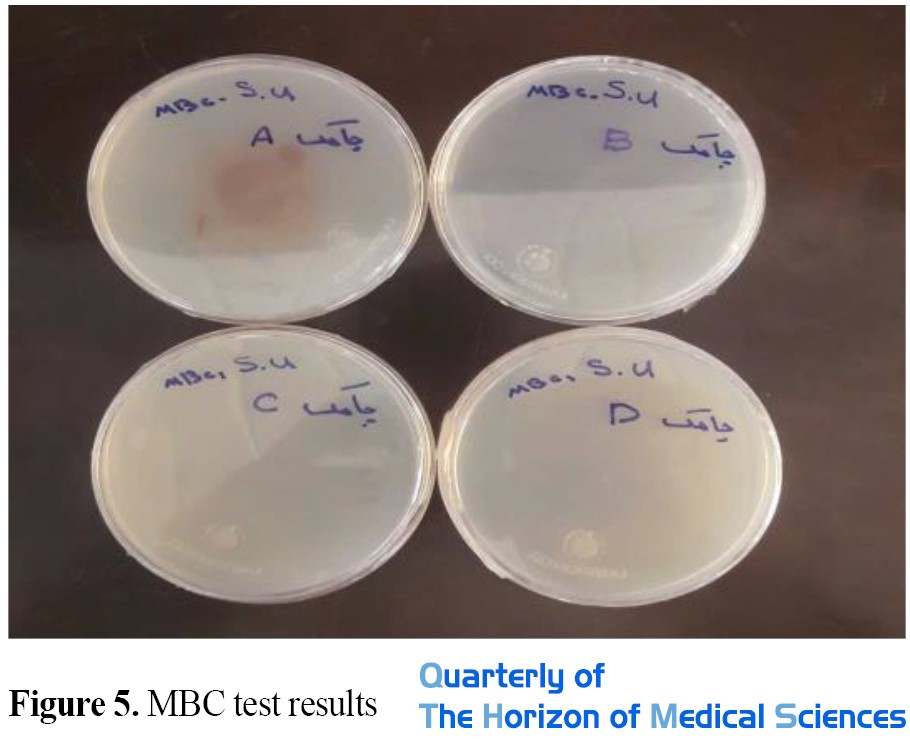

1. Introduction
Nanotechnology is the design, characterization, production, and application of materials, tools, and systems by controlling the shape and size at the nanometer scale [
1]. In recent years, the convergence between nanotechnology and biology has created a new field of nanotechnology. Nanobiotechnology is the science of using microorganisms in several biochemical and biophysical processes [
2]. This relatively new field focuses on the creation, commissioning, and use of nanoscale materials in advanced biotechnology [
3]. Compared to microorganisms, the use of plants is more efficient due to the lack of special complex and multi-stage processes such as purification, preparation, and maintenance of culture medium [
4]. Therefore, the synthesis of nanoparticles by plants is faster and cheaper in comparison to microorganisms on a larger scale [
5, 6]. Attention to the production of green nanoparticles has begun a comprehensive study showing that the use of plant extracts is the most effective way to produce environmentally friendly nanoparticles [
7, 8]. The plant extract contains active substances, which are responsible for reducing metal ions of synthesized nanoparticles [
9]. Among the advantages of using plants in the synthesis of nanoparticles are user-friendliness, biosecurity, non-toxicity, cheapness, and having a wide variety of metabolites that are involved in ion reduction [
10]. In general, the main properties of silver nanoparticles include non-toxicity, high stability, hydrophilicity, thermal resistance, non-development, and increase of resistance in microorganisms [
11]. Numerous studies have shown that the antibacterial effect of silver nanoparticles depends on their size and shape [
12,
13]. In a study by Espinosa et al., silver nanoparticles showed strong antibacterial properties against Streptococcus mutans. The results of this study showed that by reducing the size of silver nanoparticles from 100 nm to 16 nm, the minimum inhibitory concentration (MIC) is halved, which means an increase in the antibacterial properties of smaller silver nanoparticles [
14].
Today, the use of plant extracts in the synthesis of metal nanoparticles, especially silver, has received more attention [
15]. Different species of Pistaciaatlantica are grown in the world. In Iran, it grows in the provinces of Ilam, Gilan, Azerbaijan, Lorestan, Kermanshah, Hamedan, Kurdistan, Markazi, Kerman, Kerman, Fars, Tehran, Khorasan, and Sistan and Baluchestan. Extracted from a very light, thick, and very sticky green Pistaciaatlantica, it has many medicinal uses and is used as a strong laxative in the treatment of constipation and gastrointestinal disorders [
16, 17]. Also, the identification of compounds, antioxidant activity, antibacterial, and fungal effects of medicinal plants is of great interest [
1]. With the increasing use of common therapeutic antibiotics, we are witnessing the spread of antibiotic-resistant pathogenic microbial species. Paying attention to medicinal and native plants with antimicrobial effects can reduce the problems caused by antibiotics to some extent. Plant extracts and essential oils as important antimicrobial agents have been considered by many researchers in the fields of medicine and food in recent years. Among bacteria, the genus Staphylococcus belongs to the family of Micrococcus. These bacteria are gram-positive, immobile, spore-free, aerobic, and optional anaerobic [
18, 19, 20]. Staphylococci have more than 20 species that are distributed in different habitats [
21]. Bennett showed signs and symptoms of food poisoning by performing various tests and consuming milk contaminated with Staphylococcus aureus (S. aureus) [
22]. S. aureus is also a causative agent of nosocomial infections and community-acquired infections, and antibiotic-resistant S. aureus is one of the problems in the hospital and the community [
23, 24]. Studies have shown that the synthesis of green silver nanoparticles using Pistaciaatlantica extract is less well-known. Therefore, this study aimed to synthesize green silver nanoparticles from the Pistaciaathe tlantica plant against gram-positive pathogenic bacterium and optional anaerobic S. aureus PTCC 1764 resistant to antibiotics.
2. Materials and Methods
Chemicals
All chemicals used were prepared in high purity including silver nitrate (AgNO3), hydrochloric acid (HCl), and sodium hydroxide (NaOH) from the company (MERCK, Germany). Twice distilled water (Samen Serum Manufacturing Company) was used for solution and washing. In this study, the Pistaciaatlantica plant was collected from Bajestan city located in Khorasan Razavi province, and approved by a botanist.
Preparation of aqueous extract of plant
To prepare the aqueous extract, first the Pistaciaatlantica was washed well with the skin with distilled water. It was then dried at room temperature and then peeled. Then, 100 grams of peeled Pistaciaatlantica plant were washed 3 times with distilled water (Samen Serum Company) for one minute each time. Then, the sample was disinfected with 70% alcohol (MERCK, Germany) for 2 minutes and finally washed 3 times with distilled water for 2 minutes each time. To prepare the aqueous extract, the first 30 g of the studied plant was washed and placed at room temperature to dry completely. This amount of Pistaciaatlantica was then poured into an Erlenmeyer 250 mL and 100 mL of double distilled water (Samen Serum Company). The mixture was boiled for 10 minutes. The aqueous extract of Pistaciaatlantica was filtered using filter paper (Whatman, UK with 25-micron pores), and to remove suspended particles in the extract, the sample was centrifuged by centrifuge (DIGICEN21, Spain) at 9000 rpm for 10 minutes. The extract was then refrigerated (Emerson, Iran) at 4°C for later use [
25].
Synthesis of nanoparticles
Ten milliliters of the prepared Pistaciaatlantica extract was mixed with 90 ccs of 1 mM silver nitrate solution and the solution was placed on a magnetic stirrer for 24 hours at room temperature. To observe the color changes, the absorbance of the solution was examined using a spectrophotometer (Uv-Vis) model CT-5700 made in Taiwan in the range of 700-300 nm. The solution containing the nanoparticles was centrifuged at 12,000 rpm for 15 minutes (DIGICEN21, Spain) and then the supernatant was discarded [
25]. The color of the solution changes to dark brown after the nanoparticles are produced. This change is a sign of the production of silver nanoparticles. After observing the color change, the bioproduced nanoparticles were examined for better detection and characterization by other methods [
15]. To reduce the number of silver ions (Ag+) and confirm the formation of silver nanoparticles, after adding 1 mM silver nitrate solution to the extract and observing discoloration, 0.2 mL of the sample was taken and mixed with 2 mL of sterile distilled water and adsorbed. It was read by an ultraviolet-visible spectrometer at wavelengths of 700-300 nm [
25].
Antibacterial effects of silver nanoparticles
The standard microbial strain of S. aureus PTCC 1764 was prepared by the Iran Food Science and Technology Research Institute.
Diffusion disk method
To determine the antibacterial properties of the aqueous extract of Pistaciaatlantica, S. aureus lyophilized bacterium with PTCC code 1764 was first inoculated on Müller Hinton Broth (Merck, Germany), and microbial culture was incubated for 24 hours in an incubator at 37°C was placed. The above suspension was used after the vortex to prepare 0.5 McFarland. Thus, the suspension was poured into special coats of the spectrophotometer and their light absorption was determined. To produce an opacity of 0.5 McFaland, the light absorption at a wavelength of 620 nm must be 0.08-0.1, which is equivalent to colony units per milliliter of the bacterium. Then 100 μL of microbial suspension was spread on the plate containing Müller Hinton agar medium and in the next step, the extract disk with a concentration of 1000 μg/mL was placed in the plate containing culture medium. A disk containing gentamicin antibiotic (10 micrograms) made by PadtenTeb Company was used as a positive control and a disk containing a solution of deionized distilled water was used as a negative control. The plates were kept at 37°C for 24 hours and the diameter of the growth inhibition zone was measured in millimeters with a caliper and the average was recorded [
26].
Determination of minimum inhibitory concentration using microdilution (MIC) method
In this study, the microdilution broth method was used to determine the minimum inhibitory concentrations. The minimum concentration at which the extract inhibits the growth of the microorganism was tested (the concentration of the last well in which no turbidity was created). Thus, the bacterial strain of S. aureus was prepared in Müller-Hinton medium with a turbidity of 0.5 McFarland equivalent to colony unit (per ml) and after dilution, a suspension with a concentration of colony unit (per mL) was obtained. Also, from the aqueous extract of Pistaciaatlantica with a concentration of 100 μg/mL, successive dilutions were prepared in broth and 100 μL of different dilutions of the extract was poured into the microplate of 96 houses. Then, 95 μL of broth culture medium and 5 μL of bacterial suspension were added. This test was performed in three replications. Also, wells containing 200 μL of broth culture medium with bacteria were considered as a positive control, and one well-containing culture medium, bacteria, and antibiotic (gentamicin) were considered a negative control. The microplates were then boiled and incubated at 37°C for 24 hours. After 24 hours, the turbidity at a wavelength of 630 nm was read with the help of CHROMATE model 4300 ELIZARIDER made in the USA and the results were recorded and then the MIC was calculated from it (
Figure 1) [
27, 28].

Determination of minimum bactericidal concentration (MBC)
After determining the MIC, the test for determining the MBC was performed. For this purpose and to determine the minimum lethal concentration of the extract against bacteria, clear tubes in which growth was inhibited were used for culture and 50 μL of wells were removed and cultured in plates containing a solid Müller Hinton culture medium. These plates were incubated at 37°C for 72 hours, after which the lack of bacterial growth showed the minimum lethal concentration of the extract [
29].
Determination of nanoparticle size and morphology
In this study, the average size and size distribution of silver nanoparticles synthesized using ZS eutacizerDYNAMIC Light Scattering, (England Malvern) was determined as the Zen 3600 model. At this stage, the heterogeneity index (PDI) is determined, which indicates the degree of homogeneity of the size of nanoparticles in the solution [
30].
Results
Results of nanoparticle synthesis
The method of green synthesis of silver nanoparticles was performed using the reduction of silver ions by Pistaciaatlantica extract. The first sign of the production of silver nanoparticles is a change in the color of the solution. The aqueous extract of the Pistaciaatlantica plant was white in color, which began to change color after 2.5 hours after the addition of silver nitrate solution and exposure to ambient temperature indicating a high reaction rate. The dark brown color after 22 hours indicates the production of silver nanoparticles in the solution, which was consistent with the sources. The appearance of a dark brown color after a reaction with silver ions is a clear indicator of the reduction of metal ions and the formation of silver nanoparticles in the environment (
Figure 2).

When discoloration is associated with sediment formation, the formed nanoparticles are large in particle size, and when discolored and sediment is not formed, the synthesized nanoparticles are very small in part and are at their best. Sediment was not formed in any of the nanoparticle solutions produced with Pistaciaatlantica extract which indicates the appropriate particle size of Pistaciaatlantica nanoparticles. The results of ultraviolet-visible spectroscopy of Pistaciaatlantica extract after the synthesis of silver nanoparticles showed that the maximum absorption peak of the curve is in the range of 350 to 450 nm, which indicates the synthesis of silver nanoparticles (
Figure 3) [
10].

Microbial tests of silver nanoparticles
The results of disk diffusion (diameter of growth inhibition zone) were measured in millimeters with a caliper and the average was recorded. As can be seen from the results, the diameter of the S. aureus growth inhibition zone around the gentamicin antibiotic disk is 17 mm, and the diameter of the S. aureus growth inhibition zone around the disk impregnated with aqueous extract of nanoparticles of Pistaciaatlantica with a concentration of 1000 μg/mL 12 mm was observed. This means that the aqueous extract of Pistaciaatlantica nanoparticles can well inhibit the growth of S. aureus (
Figure 4 and
Table 1).


The minimum inhibitory concentration (MIC) and the lowest bactericidal concentration (MBC) of nanoparticles and Pistaciaatlantica extract were determined on S. aureus. As shown in
Table 1, in this study, the lowest inhibitory nanoparticles and extracts for Staphylococcus were 12.5 μg/mL and the lowest bactericidal concentrations of nanoparticles and extracts were determined to be 12.5 μg/mL (
Figure 5).
DLS analysis results
DLS is a fast, non-destructive physical method used to determine the particle size distribution in solution and suspension and to study the diffusion behavior of macromolecules in solution. In this study, this test was used to determine the following parameters:
Measurement of the hydrodynamic diameter of particles in suspension (Z-Average)
The results of the DLS test can be used as a complementary method for analytical studies and as a tool for the study of scattering models using the hydrodynamic radius. The diameter obtained by this method corresponds to a sphere with a transfer coefficient equivalent to the measured particle.
The transfer coefficient depends on the particle size, surface structure, concentration, and type of ions in the environment, which means that the size obtained with this method can be larger than the amount obtained by electron microscopy. The diffusion coefficient or diffusion coefficient is concentration-dependent and should be measured at different concentrations, as a standard operation, reaching infinite dilutionD0T. DT is important and very useful in determining other hydrodynamic parameters. For example, the hydrodynamic radiusRh can be obtained using the well-known Stokes-Einstein equation (
equation 1).

Rh is the hydrodynamic radius of the particle,KB, the Boltzmann constant, η is the viscosity of the solvent which is temperature-dependent and not related to the density and pressure of the system, and T is the absolute temperature and diffusion coefficient [
31].
Determining the particle size distribution using dimensionless index (PDI)
If the PDI value is less than 0.05, the particles have an excellent uniform distribution. If the PDI value is greater than 0.7, it indicates that the sample has a very wide size distribution and is probably not suitable for the DLS method, and in general, if the size of this index is between 0.1 and 0.5, the particles have a good uniform distribution [
32]. The hydrodynamic diameter size and PDI number of the sample are given in
Table 2.

As the DLS result shows, the hydrodynamic diameter of the nanoparticles is 1132 nm. The PDI value is 0.373, which indicates that the nanoparticles are in a stable state (PDI>0.7>0.1) and the particle size distribution is appropriate (
Table 3).

Accurate measurement of nanoparticle size by zetaizer: The particle size analyzer results showed that the size of the synthesized nanoparticles is 1132 nm. The diagram shows two peaks of 1132 nm and 4707 nm (
Figure 6).

The diagram shows the size distribution of nanoparticles synthesized in the optimal experiment, based on which the average of the smallest particles is 1132 nm.
Discussion
Nanosilver technology has revolutionized antibacterial materials, which are the main focus for the development of nano-silver products and have many advantages over chemicals [
33]. One of the disadvantages of chemical methods for the production of nanoparticles is the low production rate and high energies during the reaction process [
34]. However, in the green synthesis method, plant compounds are used without the need for surfactants, special conditions, and other stabilizing agents [
35]. Therefore, in this study, silver nanoparticles were produced using aqueous extracts of the Pistaciaatlantica plant by bioremediation method, and its antibacterial effects were investigated. The basis of the synthesis of nanoparticles is the reduction of their salt ions and the neutralization of the electric charge. In this study, this process was completed within 22 hours at room temperature indicating the high speed of this method and its need for high temperatures to form silver nanoparticles, which is similar to the results of research by Sivaraman et al. And Sathyavath et al [
36,
37].
Pistaciaatlantica extract with high flavonoids, alkaloids, triterpenoids, and saponins has a high potential to reduce silver nanoparticles [
38]. Oxidation of functional groups such as hydroxyl, carbonyl, and aldehyde can reduce silver ions, resulting in the production of silver nanoparticles [
39,
40].
In
Figure 2, the discoloration observed to dark brown in Pistaciaatlantica extract was a clear sign of the formation of reactive silver nanoparticles [
41] that was quite similar to the results of Reddy and Gandhi’s research [
42].
As shown in
Figure 3, the peak formed at a wavelength of 400 to 450 nm indicates the formation of silver nanoparticles related to the surface plasmon resonance of silver nanoparticles, which is attributed to the induction of free electrons in the nanoparticles [
43]. Hydrodynamic droplet size (Z-Average) and particle size distribution (PDI) were measured by the DLS method. The results showed that the size of nanoparticles synthesized using a zeta sizer is 1132 nanometers.
Two peaks can be seen in the diagram (
Figure 6), the larger peak indicates agglomeration due to the surface load between particles. The particle size distribution was 0.3, which indicates that the nanoparticles are in a stable state (PDI>0.7>0.1) and the particle size distribution is appropriate. As shown in the sample particle size distribution curve in
Figure 6, the absence of large peaks in the sample probably indicates that the nanoparticles did not form in the bulk solution implying that the nanoparticles formed well, which is consistent with the results of the research by other researchers [
44,
45].
The main mechanism of the antibacterial properties of silver nanoparticles is the release of silver ions. Some of the main mechanisms of action of silver ions are as follows: Damage to cell membranes, production of reactive oxygen species and cell attack of silver ions (or even silver nanoparticles due to membrane cavities), and further damage to ATP products and inhibition of DNA replication. In many studies, damage to the cell membrane by silver ions has been reported. These reports are mainly based on the observation of large cavities or holes in the bacterial membrane by TEM analysis. Silver ions may interact with sulfur-containing membrane proteins (eg, respiratory chain protein thiols) to cause physical damage to the membrane [
46].
The presence of strong antimicrobial effects in plant products is of particular importance because today one of the major problems of medical science is the development of resistance to antibiotics in many common pathogens [
47]. Growing antibiotic resistance increases the cost of health care due to the length of treatment (including hospitalization) and recovery, along with the failure of antibiotic treatment, the need to develop new antibiotic agents, the use of more serious methods, and wider control of infection to prevent the spread of antibiotic-resistant pathogens. With the advancement of nanotechnology and the creation of silver nanoparticles and the proven antimicrobial properties of these nanoparticles, their use in medicine and related sciences has increased dramatically [
48].
The combination of these uses with antibiotic therapy could be an important incentive for researchers to study to find, purify, and standardize effective herbal nanoproducts (which have better selective toxicity than antibiotics) such as Pistaciaatlantica. So far, many studies have been conducted to investigate the antimicrobial properties of Pistaciaatlantica gum extract. Panahi et al. investigated the effect of Pistaciaatlantica gum essential oil on the antimicrobial and antioxidant properties of starch edible film. According to the findings of this study, Pistaciaatlantica gum essential oil can be added to biodegradable films as a natural preservative [
49]. Alizadeh et al. investigated the physical and antimicrobial properties of chitosan oral film containing Pistaciaatlantica gum essential oil and the results of this study showed that Pistaciaatlantica gum essential oil as a natural antimicrobial substance has a high potential for the production of antimicrobial films [
50].
However, few studies on the antibacterial and antifungal properties of Pistaciaatlantica extract, especially the effect of nanoparticles produced using the extract of this plant on the bacterium S. aureus have been reported. Also, due to the high abundance of S. aureus in food, the role of this microorganism as one of the causes of poisoning should not be ignored. Since the enterotoxins of this bacterium are resistant to heat and protease and are not destroyed in the process of heating and cooking, the high prevalence of enterotoxin genes in this study indicates the potential role of this bacterium in causing food poisoning. The increasing prevalence and resistance to other antibiotics in CA.MRSA food-isolated strains can be a serious public health problem. Therefore, serious decisions must be made to prevent food contamination and increase the level of hygiene [
51].
The results of the study of MIC and MBC of this type of nanoparticle on S. aureus indicate that this nanoparticle has a growth inhibitory effect and a lethal effect on S. aureus. By examining the growth or non-growth of bacteria in the culture medium containing nanoparticles, the minimum inhibitory concentration was determined. A comparison of the antibacterial effect of biosynthesized nanoparticles with the extract shows that the antibacterial effect of biosynthesized nanoparticles with Pistaciaatlantica extract on this bacterium is very effective. It is expected that the good antibacterial properties of the nanoparticles synthesized in this study are due to the stable state of the formed nanoparticles (PDI> 0.7> 0.1) and the appropriate size distribution of the Pistaciaatlantica nanoparticles [
44].
In the present study, in the results obtained from the test of the average diameter of the stunted halo at a concentration of 1000 μg of Pistaciaatlantica nanoparticles on Staphylococcus, the diameter of the stunted halo was 12 mm indicating the antimicrobial properties of this plant extract. Hamelian et al. investigated the synthesis of silver nanoparticles and their antioxidant, cytotoxicity, and antibacterial effects under in vitro conditions in Pistacia atlantica leaf extract mediated showing that Ag NPs prevented the growth of all bacteria at 1-7 μg/mL concentrations and removed them at 3-15 μg/mL concentrations. Finally, synthesized Ag NPs revealed non-cytotoxicity, antioxidant, and antibacterial activities in a dose-depended manner [
2].
Sadeghi et al. investigated the facile green synthesis of silver nanoparticles using seed aqueous extract of Pistacia atlantica and its antibacterial activity. The results suggest that the synthesized Ag-NPs act as an effective antibacterial agent. It is confirmed that Ag-NPs are capable of rendering high antibacterial efficacy and hence have great potential in the preparation of used drugs against bacterial diseases [
3].
In general, gram-positive bacteria are more sensitive to plant extracts and essential oils than gram-negative bacteria. Since gram-negative bacteria have an outer layer around their cell wall and act as a barrier and limit access to hydrophobic compounds, they have less sensitivity. The findings of this study were consistent with the results of other researchers [
52]. Because of the availability of studied plants in Iran and the possibility of preparing it at a lower cost than other drugs and also due to the antibacterial properties of nanoparticles biosynthesized with extracts of these plants, the results of such research may be of interest to researchers, experts, and manufacturers of drugs and can be used to combat infections caused by these bacteria. Among nanoparticle production methods, the green production method is clean, cheap, low-risk, and environmentally friendly. The silver nanoparticles produced by this method have the potential to be used in industries related to human health due to the absence of hazardous chemicals. Therefore, a combination of the mentioned factors has caused the silver nanoparticles obtained by using the extract of this plant to have good inhibitory effects on S. aureus.
According to previous studies, it can be concluded that due to its high nutritional and medicinal properties, the Pistaciaatlantica plant can be considered a suitable option in the production of nanoparticles by green method and its application in human health-related industries such as food hygiene and treatment. The results of this study showed that Pistaciaatlantica extract in a short time can reduce silver ions in the form of nanoparticles with a suitable and stable particle size distribution, which has good inhibitory and lethal properties on S. aureus. Therefore, studying the potential of Pistaciaatlantica extract can be a solution for its effective use and a cheap and biocompatible way to produce nanoparticles.
Suggestions: According to the results obtained in this study and the good antimicrobial effect of Pistaciaatlantica nanoparticles on S. aureus, methods of reducing the particle size of Pistaciaatlantica silver nanoparticles and their evaluation with other methods of measuring nanoparticles and their antimicrobial effect are recommended for other gram-positive bacteria to find more information and make optimal use of this unique plant.
Ethical Considerations
Compliance with ethical guidelines
There were no ethical considerations to be considered in this research.
Funding
This research is a group research work of Mr. Dr. Jalal Mardane, a member of the Department of Microbiology, Faculty of Medicine, Infectious Diseases Research Center, Gonabad University of Medical Sciences, Elaha Moradi, a graduate of Master's in Food Science and Technology, and students of Shahed Reihaneh Al-Nabi High School, Gonabad city, which Financial support has been provided by the honorable management of Shahed Reihaneh Al-Nabi High School.
Authors' contributions
Conceptualization and methodology: Elaha Moradi; Research, data collection, writing - draft and original: all authors; data analysis: Elaha Moradi; Funding and editing of references: All authors.
Conflicts of interest
The authors of this article declare no conflict of interest.
Acknowledgements
The authors consider it necessary to express their gratitude to the management of Reyhaneh Al-Nabi Girls’ High School in Gonabad, Miss Moradi. Also, the cooperation of the esteemed director of the Central Laboratory of the Food Science and Technology Research Institute of Khorasan Razavi, Dr. Faizi, and his colleagues is appreciated.
References
- Ponce Del Castillo. The European and member states’ approaches to regulating nanomaterials: Two levels of governance. Nanoethics. 2013; 7:189–99. [DOI:10.1007/s11569-013-0181-7]
- Dwivedi AD, Gopal K. Biosynthesis of silver and gold nanoparticles using Chenopodium album leaf extract. Colloids and Surfaces A: Physicochemical and Engineering Aspects. 2010; 369(1-3):27-33.[DOI:10.1016/j.colsurfa.2010.07.020]
- Martin-Sanchez F, Maojo V. Biomedical informatics and the convergence of Nano-Bio-Info-Cogno (NBIC) technologies. Yearb Med Inform. 2009; 134-42. [PMID]
- Shah M, Fawcett D, Sharma S, Tripathy SK, Poinern GEJ. Green synthesis of metallic nanoparticles via biological entities. Materials. 2015; 8(11):7278-308. [DOI:10.3390/ma8115377] [PMID] [PMCID]
- Makarov VV, Love AJ, Sinitsyna OV, Makarova SS, Yaminsky IV, Taliansky ME, et al. Green nanotechnologies: Synthesis of metal nanoparticlesusing plants. Acta Naturae. 2014; 6(1):35-44. [DOI:10.32607/20758251-2014-6-1-35-44] [PMID] [PMCID]
- Shankar SS, Rai A, Ahmad A, Sastry M. Rapid synthesis of Au, Ag, and bimetallic Au core-Ag shell nanoparticles using Neem (Azadirachta indica) leaf broth. Journal of Colloid and Interface Science. 2004; 275(2):496-502. [DOI:10.1016/j.jcis.2004.03.003] [PMID]
- Singh M, Kumar M, Kalaivani R, Manikandan S, Kumaraguru AK. Metallic silver nanoparticle: A therapeutic agent in combination with antifungal drug against human fungal pathogen. Bioprocess and Biosystems Engineering. 2013; 36(4):407-15. [DOI:10.1007/s00449-012-0797-y] [PMID]
- Protima R, Rauwel E. Emerging trends in nanoparticle synthesis using plant extracts for biomedical applications. Globalal Journal of Nanomedicine. 2017; 1(3):555562. [DOI:10.19080/GJN.2017.01.555562]
- Li X, Xu H, Chen ZS, Chen G. Biosynthesis of nanoparticles by microorganisms and their applications. Journal of Nanomaterials. 2011; 2011:1-16. [DOI:10.1155/2011/270974]
- Roy N, Barik A. Green synthesis of silver nanoparticles from the unexploited weed resources. International Journal of Nanotechnology and Applications. 2010; 4(2):95-101. [Link]
- Percival SL, Bowler PG, Dolman J. Antimicrobial activity of silver-containing dressings on wound microorganisms using an in vitro biofilm model. International Wound Journal. 2007; 4(2):186-91. [DOI:10.1111/j.1742-481X.2007.00296.x] [PMID] [PMCID]
- Guzman M, Dille J, Godet S. Synthesis and antibacterial activity of silver nanoparticles against gram-positive and gram-negative bacteria. Nanomedicine: Nanotechnology, Biology and Medicine. 2012; 8(1):37-45. [PMID]
- Pal S, Tak YK, Song JM. Does the antibacterial activity of silver nanoparticles depend on the shape of the nanoparticle? A study of the gram-negative bacterium Escherichia coli. Applied and Environmental Microbiology. 2007; 73(6):1712-20. [PMID] [PMCID]
- Espinosa-Cristóbal LF, Martínez-Castañón GA, Martínez-Martínez RE, Loyola-Rodriguez JP, Patino-Marin N, Reyes-Macías JF, et al. Antibacterial effect of silver nanoparticles against Streptococcus mutans. Materials Letters. 2009; 63(29):2603-6. [DOI:10.1016/j.matlet.2009.09.018]
- Gnanadesigan M, Anand M, Ravikumar S, Maruthupandy M, Ali SM, Vijayakumar V, et al. Antibacterial potential of biosynthesised silver nanoparticles using Avicennia marina mangrove plant. Applied Nanoscience. 2012; 2:143–7. [DOI:10.1007/s13204-011-0048-6]
- Jafari Kokhdan A, Zarifian A. [Floristic study of saverz mountain in kohgiloyeh and boyerahmad province (Persian)]. Journal of Plant Research (Iranian Journal of Biology). 2016; 28(5):929-51. [Link]
- Doosti B. [The comparison of antibacterial and antifungal effects of Pistacia atlantica gum with some inuse antibiotics (Persian)]. Journal of Cellular and Molecular Research (Iranian Journal of Biology). 2019; 32(1):115-24. [Link]
- Kiaei E, Mazandarani MA, Ghaemi E. Antibacterial activity of 7 species of medicinal plants on bacteria isolated from UTI patients in Golestan province. Journal of Medicinal plants. 2010; 9(34). [Link]
- Nejati V, Khaneshi F. [Effect of hydro-alcoholic extract of plantago major leaf on serum level of insulin, glucose, and histology of pancreas and kidney in streptozotocin-induced diabetic rats (Persian)]. Qom University of Medical Sciences Journal. 2013; 7(5):14-20. [Link]
- Hennekinne JA, De Buyser ML, Dragacci S. Staphylococcus aureus and its food poisoning toxins: Characterization and outbreak investigation. FEMS Microbiology Reviews. 2012; 36(4):815-36. [DOI:10.1111/j.1574-6976.2011.00311.x] [PMID]
- Roesch M, Perreten V, Doherr MG, Schaeren W, Schällibaum M, Blum JW. Comparison of antibiotic resistance of udder pathogens in dairy cows kept on organic and on conventional farms. Journal of Dairy Science. 2006; 89(3):989-97. [DOI:10.3168/jds.S0022-0302(06)72164-6]
- Bennett RW, Yeterian M, Smith W, Coles CM, Sassaman M, McClure FD. Staphylococcus aureus identification characteristics and enterotoxigenicity. Journal of Food Science. 1986; 51(5):1337-39. [DOI:10.1111/j.1365-2621.1986.tb13117.x]
- Imani Fouladi AA, Choupani A, Fallah Mehrabadi J. [Study of prevalence of Enterotoxin type B gene in Meticillin Resistant Staphylococcus aureus (MRSA) isolated from wound (Persian)]. Kowsar Medical Journal. 2011; 16(1):21-5. [Link]
- Charlebois ED, Perdreau-Remington F, Kreiswirth B, Bangsberg DR, Ciccarone D, Diep BA, et al. Erratum: Origins of community strains of methicillin-resistant Staphylococcus aureus. Clinical Infectious Disease. 2004; 39(1):47-54. [PMID]
- Kannan RRR, Arumugam R, Ramya D, Manivannan, Anantharaman P. Green synthesis of silver nanoparticles using marine macroalga Chaetomorpha linum. Applied Nanoscience. 2013; 3:229-33. [DOI:10.1007/s13204-012-0125-5]
- Houshmand B, Mortazavi H, Alikhani Y, Abdolsamadi H, AhmadiMotemayel F, ZareMahmoudabadi R. [In vitro evaluation of antibacterial effect of myrtus extract with different concentrations on some oral bacteria (Persian)]. Journal of Mashhad Dental School. 2011; 35(2):123-30. [DOI:10.22038/JMDS.2011.970]
- Kermanshah H, Hashemi Kamangar S, Arami S, Mirsalehian A, Kamalinegad M, Karimi M et al. [Comparison of antibacterial effect of hydroalcoholic extract of four plants against cariogenic microorganisms by two in vitro Methods (Persian)]. Journal of Babol University of Medical Sciences. 2011; 13(6):21-9. [Link]
- Shahverdi AR, Minaeian S, Shahverdi HR, Jamalifar H, Nohi AA. Rapid synthesis of silver nanoparticles using culture supernatants of Enterobacteria: A novel biological approach. Process Biochemistry. 2007; 42(5):919-23. [DOI:10.1016/j.procbio.2007.02.005]
- Mahmoudi R, Ehsani PA, Tajik H, Akhoundzadeh BA, Khosroshahi A. [Antimicrobial effects of Mentha longifolia L. essential oil and Lactobacillus casei against Staphylococcus aureus in Iranian white cheese (Persian)]. Journal of Food Research. 2010; 3(1):147-61.[Link]
- Ghodrat IZ, Divsalar A, Ayrian S, Saeidifar M. [Evaluation of the anticancer effects of Samarium nanoparticles synthesized by extract of ginger on HCT116 colorectal cancer cells (Persian)]. Journal of Cell & Tissue. 2020; 10(4):202-13. [Link]
- Stetefeld J, McKenna SA, Patel TR. Dynamic light scattering: A practical guide and applications in biomedical sciences. Biophysical Reviews. 2016; 8(4):409-27. [PMID] [PMCID]
- Singh LP, Bhattacharyya SK, Kumar R, Mishra G, Sharma U, Singh G, et al. Sol-Gel processing of silica nanoparticles and their applications.Advances in Colloid and interface Science. 2014; 214:17-37. [PMID]
- Esmaile F, Koohestani H, Abdollah-Pour H. Characterization and antibacterial activity of silver nanoparticles green synthesized using Ziziphora clinopodioides extract. Environmental Nanotechnology, Monitoring & Management. 2020; 14:100303. [DOI:10.1016/j.enmm.2020.100303]
- Kavoosi S, Yaghoubi H. [Synthesis of silver nanoparticles using green method of plant extract european marjoram (origanum majorana) and their antibacterial effects (Persian)]. Journal of Cellular and Molecular Research (Iranian Journal of Biology). 2017; 30(2):161-73. [Link]
- Mittal AK, Chisti Y, Banerjee UC. Synthesis of metallic nanoparticles using plant extracts. Biotechnology Advances. 2013; 31(2):346-56. [PMID]
- Sivaraman SK, Elango I, Kumar S, Santhanam V. A green protocol for room temperature synthesis of silver nanoparticles in seconds.Current Science (00113891). 2009; 97(7):1055-9. [Link]
- Sathyavathi R, Krishna MB, Rao SV, Saritha R, Rao DN. Biosynthesis of silver nanoparticlesusing Coriandrum sativum leaf extract and their application in nonlinear optic. Advanced science letters. 2010; 3(2):138-43. [DOI:10.1166/asl.2010.1099]
- Nikbakht MR, Soleimani Z, Moravveji SA, Esalatmanesh K. [Evaluating the effectiveness of Pistacia atlantica in the improvement of diabetic foot (Persian)]. Feyz. 2016; 20(4):347-51. [Link]
- Talpur AD. Mentha piperita (Peppermint) as feed additive enhanced growth performance, survival, immune response and disease resistance ofAsian seabass, Lates calcarifer (Bloch) against Vibrio harveyi infection. Aquaculture. 2014; 420-421:71-8. [DOI:10.1016/j.aquaculture.2013.10.039]
- Douglas JA, Douglas MH, Lauren DR, Martin RJ, Deo B, Follett JM, et al. Effect of plant density and depth of harvest on the production and quality of licorice (Glycyrrhiza glabra) root harvested over 3 years. New Zealand Journal of Crop and Horticultural Science. 2004; 32(4):363-73. [DOI:10.1080/01140671.2004.9514317]
- Jegadeeswaran P, Shivaraj R, Venckatesh R. Green synthesis of silver nanoparticles from extract of Padina tetrastromatica leaf. Digest Journal of Nanomaterials and Biostructures. 2012; 7(3):991-8. [Link]
- Reddy GR, Gandhi NN. Environmental friendly biosynthesis, characterization and antibacterial activity of silver nanoparticles by using Senna Saimea plant leaf aqueous extract. Int J Iins Pharm Life Sci. 2012; 2(1):186-93. [Link]
- Zeng Q, Jiang X, Yu A, Lu GM. Growth mechanisms of silver nanoparticles: A molecular dynamics study. Nanotechnology. 2007; 18(3):035708. [PMID]
- Ragheb G, Najmoddin N, Aleemardani M. [The effect of synthesis parameters on the particle size, particle size distribution and hydrodynamic diameter of silica nanoparticles via modified StÖber method (Persian)]. Nanomaterials. 2018; 10(34):117-28. [Link]
- Razmi A, Nikkhah M, Bagheri A, Malekzadeh Shafaroudi S, Shams bakhsh M. [Green syntesis of spherical gold nano particle by Water cress (Persian)]. Modares Journal of Biotechnology. 2017; 8(1):60-70. [Link]
- Moadi T, Ghahremanzadeh R, Yosefi M, Mohammadi F. [Synthesis of silver nanoparticles (Ag NPs) via four kinds of plants extract and investigation of antimicrobial activity of these nanoparticles (Persian)]. Nashrieh Shimi va Mohandesi Shimi Iran. 2014; 33(4):1-9. [Link]
- Jansen WT, van der Bruggen JT, Verhoef J, Fluit AC. Bacterial resistance: A sensitive issue complexity of the challenge and containment strategy in Europe. Drug Resistance Updates. 2006; 9(3):123-33. [PMID]
- Moghtader M, Salari H, Mozafari H, Farahmand A. [Evaluation the qualitative and quantitative essential oil of Calendula officinalis and its antibacterial effects (Persian)]. Journal of Molecular and Cellular Research. 2016; 29(3):331-9. [Link]
- Panahi M, Barzegar H, Hojjati M. [Effect of pistacia atlantica gum oil on antimicrobial and antioxidant properties of edible starch film (Persian)]. Innovative Food Technologies. 2017; 5(1):77-89. [DOI:10.22104/jift.2017.462]
- Alizadeh V, , Barzegar H, Nasehi B, Samavati V. [Characterization of physical and antimicrobial properties of chitosan edible films containing pistacia atlantica gum essence (Persian)]. Iranian Food Science and Technology Research. 2017; 13(4):584 -93. [Link]
- Hoseiyni SM, Arabestani MR, Mahmoodi H, Farhangara E. [Prevalence of G, H, I, J Enterotoxin Genes and Antibacterial Susceptibility Pattern in Staphylococcus aureus strains Isolated from Different Foods (Persian)]. Journal of Mazandaran University of Medical Sciences. 2015; 25(123):1-10. [Link]
- Alizadeh Behbahani B, Shahidi F, Tabatabaei Yazdi F, Mortazavi SA, Mohebbi M. [The antimicrobial effect and interaction of aqueous and ethanolic extracts of Plantago major on Staphylococcus aureus, Listeria inocua, Escherichia coli and Pseudomonas aeruginosa in vitro (Persian)]. Iranian Journal of Infectious Diseases and Tropical Medicine. 2017; 21(75):1-8. [Link] .